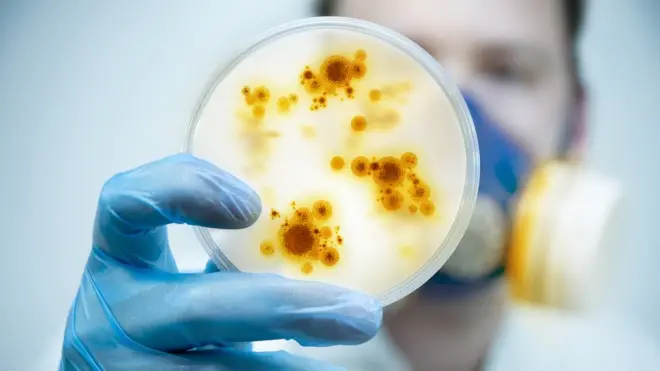
Placa con un cultivo.

Cómo es el alarmante brote de fiebre amarilla en Brasil y qué posibilidades hay de que se convierta en una epidemia

Fuente de la imagen, Reuters
- Autor, Redacción
- Título del autor, BBC Mundo
El virus de la fiebre amarilla existe en Brasil desde los tiempos coloniales.
Sin embargo, desde el año pasado, el número de casos ha ido aumentando hasta alcanzar niveles sin precedentes en los últimos 50 años.
El viernes pasado, el Ministerio de Salud de Brasil informó que en los últimos siete meses y medio 464 personas contrajeron fiebre amarilla, de las cuales 154 murieron.
Los datos fueron actualizados por última vez hace tan solo 10 días. En ese período murieron 56 persona y se confirmaron 111 casos nuevos.

Fuente de la imagen, Getty Images
A pesar de las campañas de vacunación implementadas actualmente en los estados de Sao Paulo, Río de Janeiro, Minas Gerais, Espírito Santo y Bahía, el alarmante brote de esta enfermedad no parece ceder en Brasil.
Pero ¿puede llegar a convertirse en una epidemia?
De la selva a la ciudad
La fiebre amarilla es una enfermedad causada por un virus transmitido por la picadura de mosquitos infectados y que no se contagia entre humanos.

Fuente de la imagen, Getty Images
Según la Organización Mundial de la Salud (OMS), "una pequeña proporción de pacientes infectados presentan síntomas graves y aproximadamente la mitad de estos fallecen en un plazo de 7 a 10 días".
Uno de los problemas que presenta la enfermedad es su difícil diagnóstico, ya que muchos casos no se manifiestan físicamente. Cuando hay síntomas, se dan fiebre, cefaleas, dolores musculares, náuseas, vómitos y cansancio.
No obstante existe otro síntoma que ayuda a la rápida detección: la ictericia, coloración amarillenta de la piel y mucosas que da nombre a la enfermedad.
A nivel epidemiológico, la verdadera gravedad de la fiebre amarilla se mide en función de los ciclos de transmisión.
Por un lado está la etapa llamada selvática o silvestre, que es aquella que contraen las personas en zonas rurales o selváticas por picaduras de mosquitos de los géneros Haemagogus y Sabethes.


Y, por otro lado, está el ciclo urbano, transmitido por mosquitos Aedes aegypti infectados.
"Las grandes epidemias se producen cuando las personas infectadas introducen el virus en zonas muy pobladas, con gran densidad de mosquitos y donde la mayoría de la población tiene escasa o nula inmunidad por falta de vacunación", explica la OMS.
"Mucha suerte"
Ricardo Lourenço, investigador del centro científico Instituto Oswaldo Cruz de Río de Janeiro, explicó a la BBC que a principios de la década del 2000, algunos casos de fiebre amarilla comenzaron a resurgir en áreas de la Mata Atlántica, es decir, en zonas selváticas de las costas brasileñas.
A partir de diciembre de 2016, el número de infectados estalló en algunas regiones de Minas Gerais y Espírito Santo.
Pero fue entre 2017 y 2018, cuando los casos de fiebre amarilla crecieron rápidamente en Río de Janeiro y en Sao Paulo, que el brote puso en alerta al gobierno y a organismos internacionales.

Fuente de la imagen, Getty Images
Eduardo Massad, médico epidemiólogo de la Universidad de Sao Paulo, dijo a la BBC: "La situación en que estamos es de mucha suerte", debido a la baja cantidad de mosquitos Aedes aegypti registrada este año en Sao Paulo.
Sao Paulo, la zona metropolitana con mayor población de Brasil, es el estado más golpeado por la fiebre amarilla después de Minas Gerais, el lugar donde se originó el actual brote.
Sin embargo, el Ministerio de Salud asegura que la posibilidad de una transmisión urbana es "baja".
"Ya hay un programa nacionalmente establecido de control del Aedes aegypti en función de otras arbovirosis (dengue, zika, chikungunya), que logra mantener niveles de infestación por debajo de lo que los estudios consideran necesario para sostener una transmisión urbana de fiebre amarilla", aseguraron las autoridades.
Varios especialistas consultados por BBC Brasil coincidieron en que las posibilidades de que la fiebre amarilla se convierta en una epidemia son muy pequeñas, aunque no se descarta.

Fuente de la imagen, Getty Images
De acuerdo con dichos especialistas, este bajo riesgo da el tiempo suficiente para que la población sea vacunada antes de una posible transmisión masiva de la enfermedad.
Vacunación y tratamiento
"La vacuna es la medida más eficaz para combatir la enfermedad y evitar casos y muertes", afirmó el ministro de Salud brasileño, Ricardo Barros, la semana pasada.
"Toda la población que vive en los municipios donde está ocurriendo la campaña debe inmunizarse", agregó.
Incluso este lunes las autoridades comenzaron a vacunar en Bahía aún antes de que se detectara ningún caso.
Según el Ministerio de Salud, en los estados de Sao Paulo y Río ya se vacunaron 4,3 millones de personas, aunque el objetivo oficial es llegar a las 20,4 millones.
Desde enero, la OMS aconseja la vacunación a todos los que viajen a Sao Paulo, ampliando la recomendación ya existente para los estados de las regiones centro oeste y norte de Brasil, Minas Gerais, Río de Janeiro, Espírito Santo y Maranhão, además de partes de los estados de la región sur, Bahía y Piauí.
Pese a ello, el jueves pasado un turista chileno de 35 años murió en un hospital de Río de Janeiro tras contraer la enfermedad.

Fuente de la imagen, Getty Images
Si bien no hay un tratamiento antivírico específico para la fiebre amarilla, la tasa de supervivencia es mayor cuando se recibe asistencia temprana en un hospital para la deshidratación, la insuficiencia hepática y renal y la fiebre.
¿Y los monos?
En los últimos meses han aparecido fotos de monos muertos en los estados brasileños afectados por la fiebre amarilla.
Catalogados como "centinelas" y "mártires" por los especialistas consultados por BBC Brasil, los monos son el blanco preferido de los mosquitos silvestres que transmiten la fiebre amarilla, que suelen volar a la altura de la copa de los árboles.
Muchos primates acaban desarrollando la enfermedad y mueren.
Sin embargo, la mayoría están siendo víctimas de la desinformación: son ejecutados con piedras, palos o veneno por quienes creen que pueden transmitir la enferemdad.
Solo este año, de los 144 monos muertos recogidos por Vigilancia Sanitaria y Control de Zoonosis de Río de Janeiro para pruebas de fiebre amarilla, 69% fueron ejecutados. El año pasado esta estadística ascendía al 42%.

Fuente de la imagen, Getty Images
Además de cruel, la medida tiene un efecto contrario al imaginado por muchas personas, ya que, por ejemplo, ante la disminución poblacional de monos, los mosquitos picarían aún más a los humanos.
Pensando a futuro, Massad aseguró que el gobierno se equivoca al no considerar la posibilidad de vacunar a los monos que viven en la Mata Atlántica.
El epidemiólogo calculó que con un pequeño porcentaje del dinero gastado para inmunizar a la población humana de Sao Paulo, sería posible vacunar a los 50.000 monos que viven en Sao Paulo.
El coordinador de Control de Enfermedades del Ministerio de Salud, Marcos Boulos, coincidió en que vacunar monos sería lo ideal, pero dice que eso es inviable.
"La prioridad número uno es vacunar a las personas (que viven en las regiones) donde circula el virus. La segunda son las regiones receptivas, donde hay mosquitos Haemagogus y monos", dijo Boulos.
"La tercera y última es el resto de la población, que no corre el riesgo, pero puede ir a una de esas áreas".

Ahora puedes recibir notificaciones de BBC Mundo. Descarga la nueva versión de nuestra app y actívalas para no perderte nuestro mejor contenido.